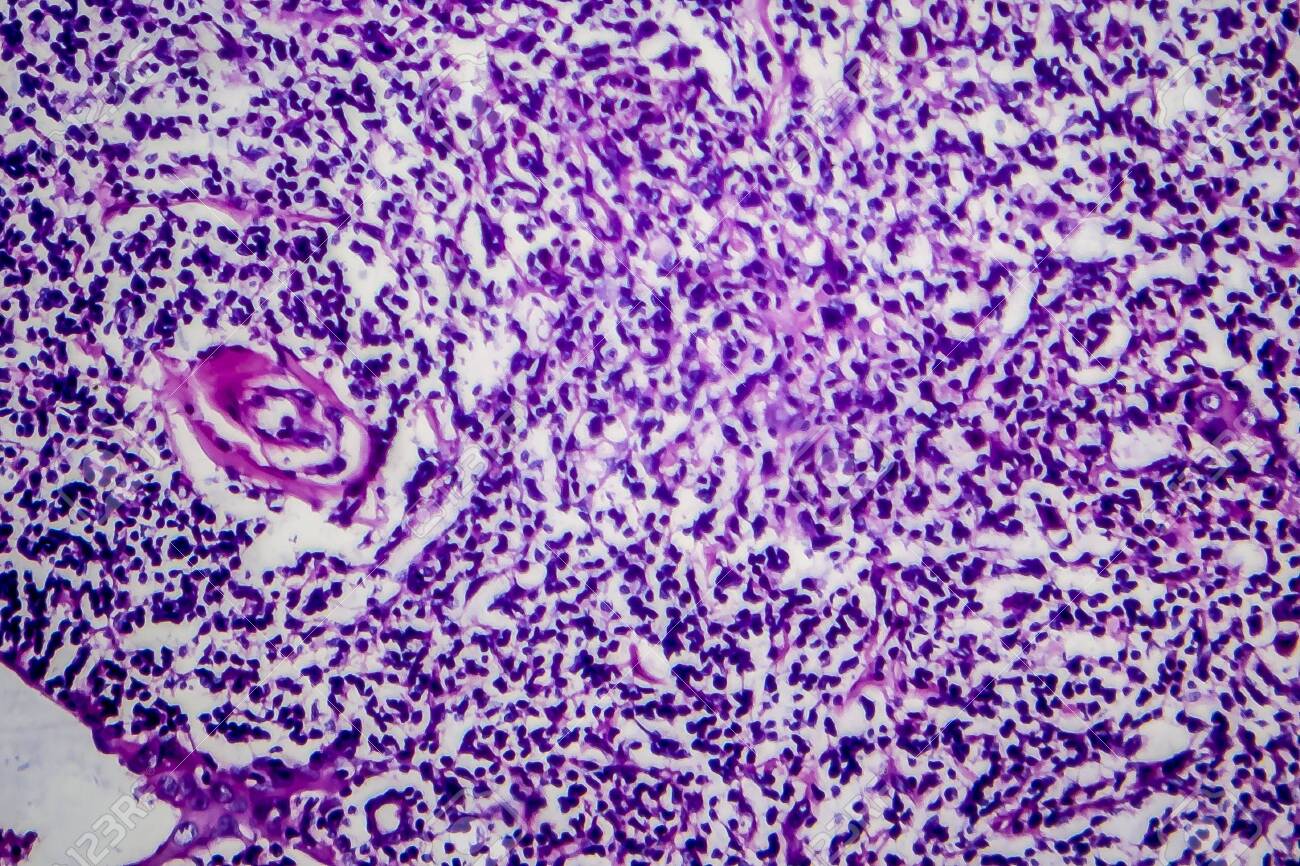
etiam-dictum-ipsum-a-felis

Download
Close
Автор:
id:
Ключевые слова:
cancer, cell, eosin, hematoxylin, histology, hodgkin, lymphatic, lymphoma, lypmphocyte, magnification, malignant, medical, medicine, micro, micrograph, microphotograph, microscope, microscopic, microscopy, morphological, morphology, neoplasia, neoplasm, oncology, pathology, photomicrograph, stain, tissue, tumor,





